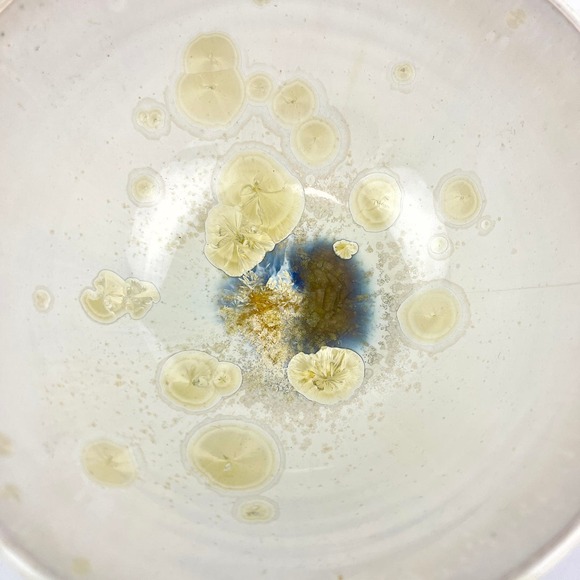
White Porcelain Crystalline Glazed 5.5in Bowl Hand Thrown - Picture 3 of 8

White Porcelain Crystalline Glazed 5.5in Bowl Hand Thrown
$25
Size
Like and save for later
Add To Bundle
Beautiful crystalline glazed bowl measures approx 5.5" across and 2.5" high. Signed by artist. There is a hairline crack as pointed out in photo.
Shipping/Discount


madisonmaholm
and
one other
like this
Trending Now
Find Similar Listings
Account is under Review
Comment posting is temporarily restricted. Our team will reach out to you shortly. To understand why, select
Learn More.